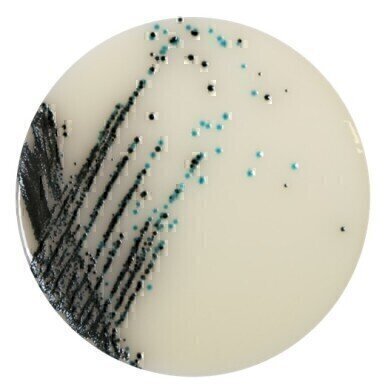
Neogen Develops Superior Chromogenic Media for Salmonella

Laboratory products
Neogen Develops Superior Chromogenic Media for Salmonella
Jan 19 2017
Neogen’s Lab M has developed a unique chromogenic media that offers a superior ability to simultaneously detect numerous strains of Salmonella of concern to the food and animal feed industries, while inhibiting or minimising other organisms.
This new Chromogenic Agar for Salmonella Esterase (CASE) uses a proprietary dual chromogenic system to differentiate between Salmonella and non-target organisms that grow on the agar. The new media, available in pre-poured plate or dehydrated culture media (DCM), is suitable for use within the ISO 6579 protocol - the international standard for testing food and animal feed for Salmonella species.
“Currently available Salmonella chromogenic media typically produce pink purple colonies that are sometimes hard to distinguish — whilst this new agar gives turquoise-blue and black colonies that are very easy to identify particularly with low C8-esterase activity Salmonella strains,” said Steve Chambers, Neogen’s European Sales and Marketing Director. “CASE media also is able to detect specific Salmonella serovars that are often missed by existing media, including non motile and weaker strains such as S. Dublin, reducing the risk of reading false negative results. The media was developed at Neogen’s Lab M facilities specifically for food and animal feed manufacturers, as well as poultry and pork producers and processors.”
CASE detects a wide range of Salmonella species and has been shown to produce enhanced specificity in the detection of important Salmonella serotypes, including S. Gallinarum, S. Pullorum and S. Dublin. Additionally the formulation of CASE means growth from background flora is significantly reduced and closely related Enterobacteriaceae, such as Citrobacter and Enterobacter, are clearly defined. This makes difficult matrices easier to read and can significantly reduce the amount of unnecessary confirmations required which can be costly and time-consuming.
Neogen can supply the CASE media fully ready to use as part of Lab M’s Pinnacle™ pre-poured media range, which includes all necessary supplements with no need to weigh, cool or autoclave media. Alternatively, the CASE media is available pre-supplemented in DCM format as part of Lab M’s Harlequin™ chromogenic media range.
Digital Edition
Lab Asia Dec 2025
December 2025
Chromatography Articles- Cutting-edge sample preparation tools help laboratories to stay ahead of the curveMass Spectrometry & Spectroscopy Articles- Unlocking the complexity of metabolomics: Pushi...
View all digital editions
Events
Jan 21 2026 Tokyo, Japan
Jan 28 2026 Tokyo, Japan
Jan 29 2026 New Delhi, India
Feb 07 2026 Boston, MA, USA
Asia Pharma Expo/Asia Lab Expo
Feb 12 2026 Dhaka, Bangladesh